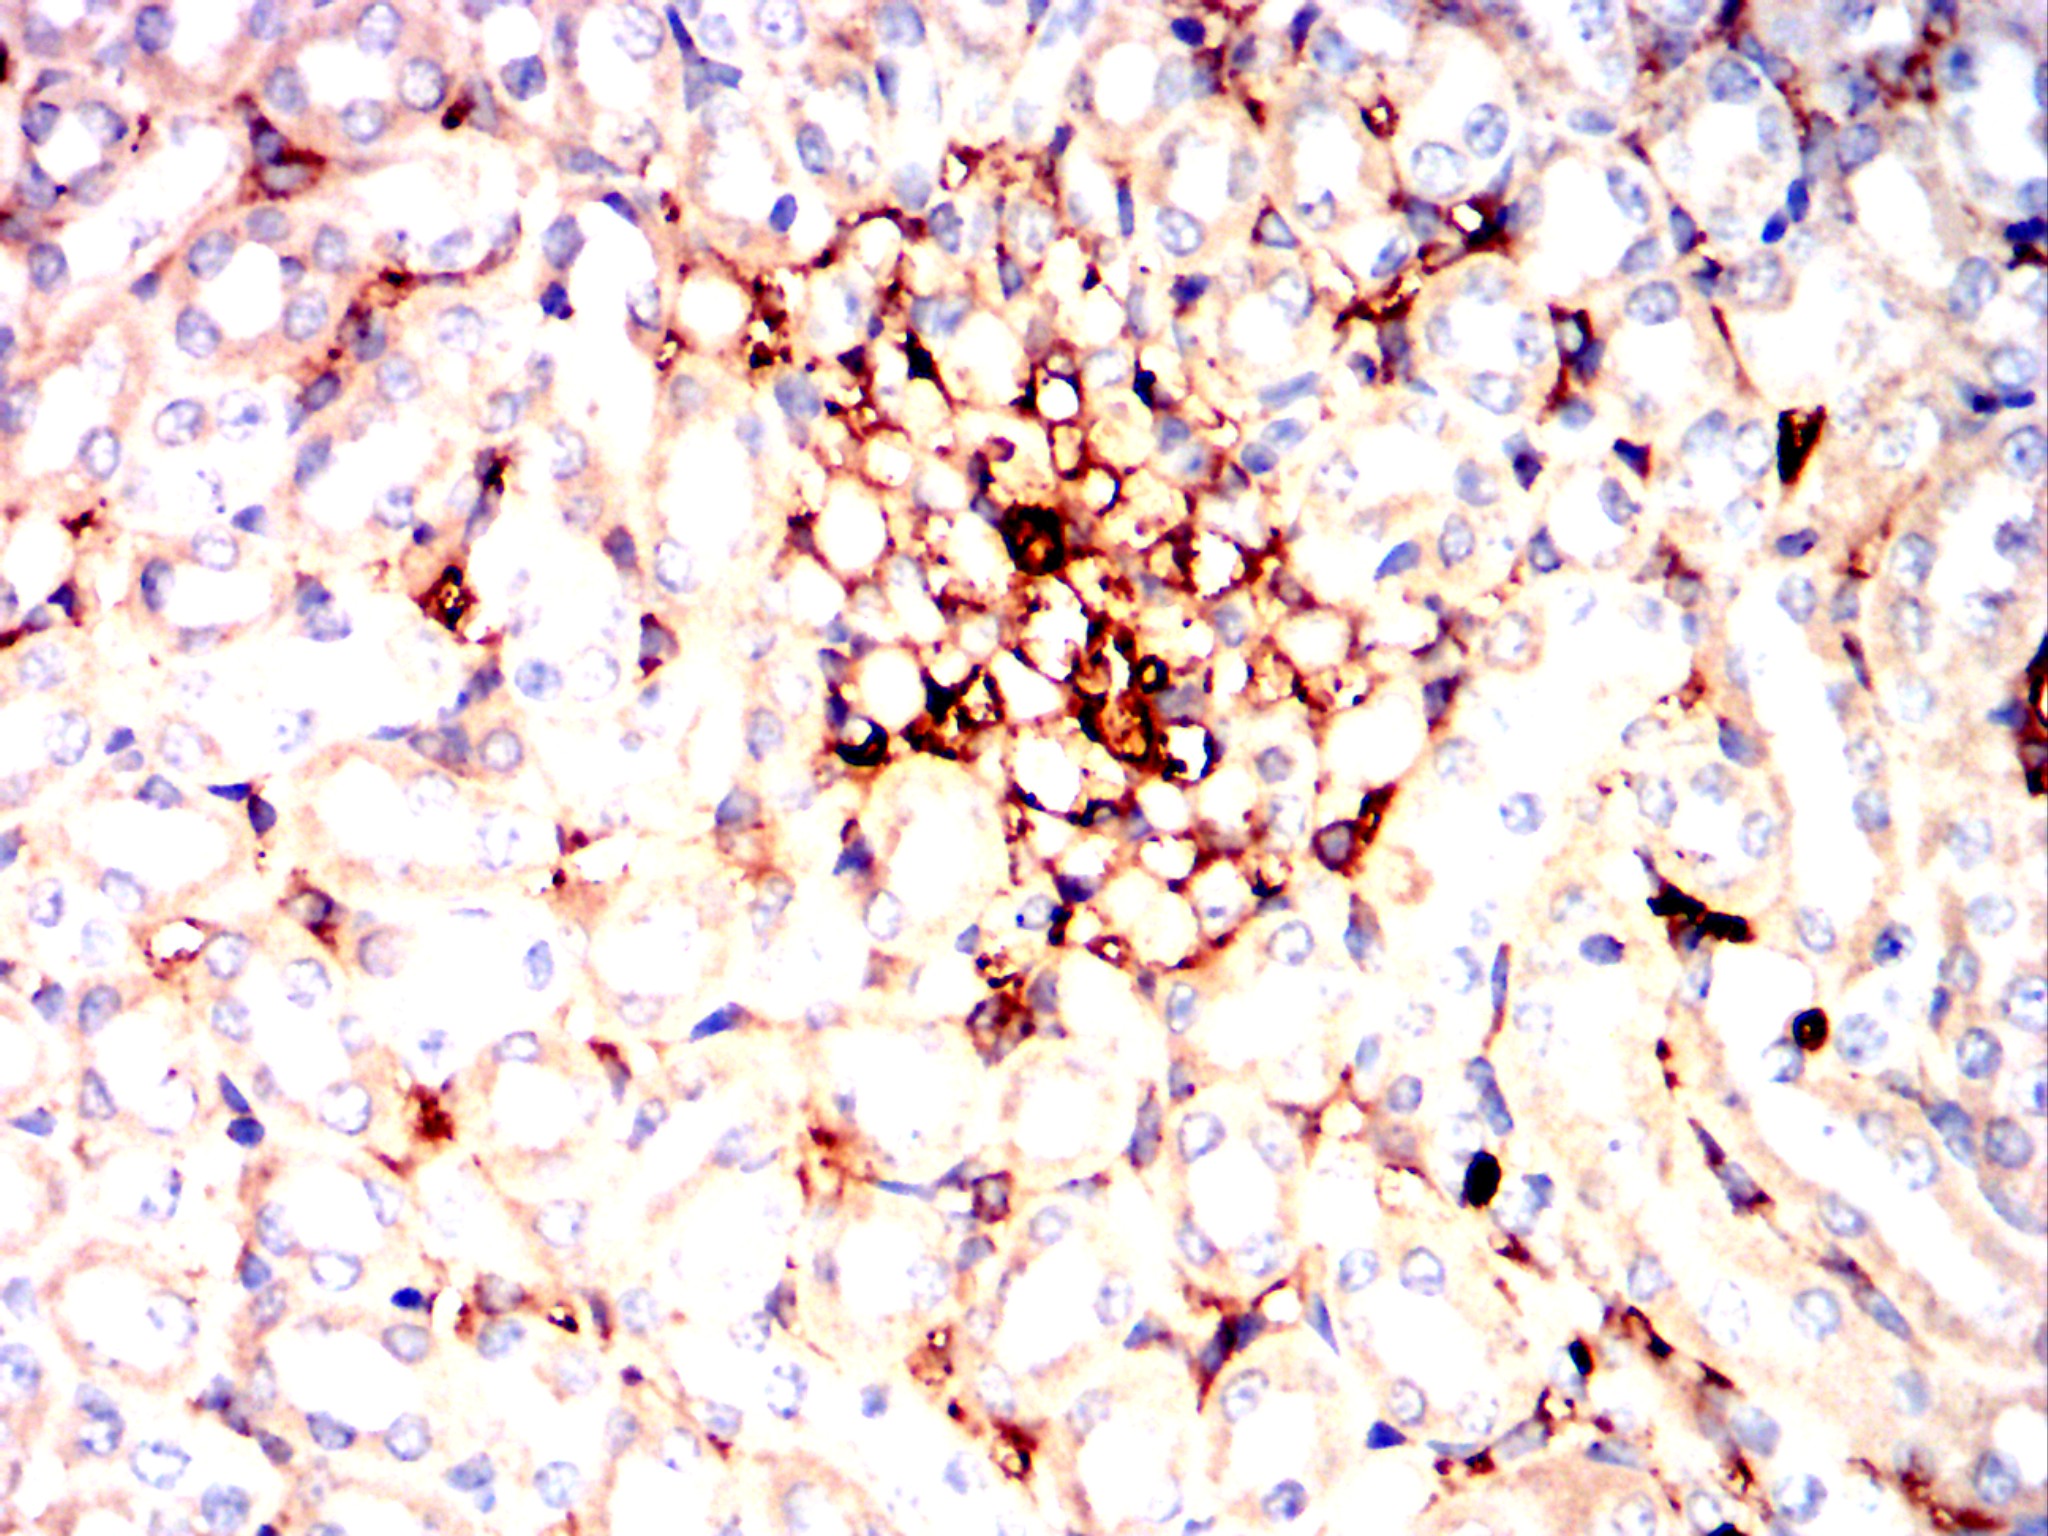

Mouse Monoclonal Antibody to CHRNA7
货号:
31258
别名:
NACHRA7; CHRNA7-2
应用:
IHC,FCM
反应种属:
Human,Mouse,Rat,Rabbit
抗体类型:
Primary antibody
Swissprot:
P36544
规格:
目录价
在线咨询
Description |
|---|
The nicotinic acetylcholine receptors (nAChRs) are members of a superfamily of ligand-gated ion channels that mediate fast signal transmission at synapses. The nAChRs are thought to be hetero-pentamers composed of homologous subunits. The proposed structure for each subunit is a conserved N-terminal extracellular domain followed by three conserved transmembrane domains, a variable cytoplasmic loop, a fourth conserved transmembrane domain, and a short C-terminal extracellular region. The protein encoded by this gene forms a homo-oligomeric channel, displays marked permeability to calcium ions and is a major component of brain nicotinic receptors that are blocked by, and highly sensitive to, alpha-bungarotoxin. Once this receptor binds acetylcholine, it undergoes an extensive change in conformation that affects all subunits and leads to opening of an ion-conducting channel across the plasma membrane. This gene is located in a region identified as a major susceptibility locus for juvenile myoclonic epilepsy and a chromosomal location involved in the genetic transmission of schizophrenia. An evolutionarily recent partial duplication event in this region results in a hybrid containing sequence from this gene and a novel FAM7A gene. Alternative splicing results in multiple transcript variants. |
References |
|---|
| 1.Neuromolecular Med. 2015 Dec;17(4):423-30. 2.Eur J Hum Genet. 2015 Aug;23(8):1019-24. |
Specification |
|
|---|---|
| Aliases | NACHRA7; CHRNA7-2 |
| Entrez GeneID | 1139 |
| Swissprot | P36544 |
| clone | 7F10G1 |
| WB Predicted band size | 56.4kDa |
| Host/Isotype | Mouse IgG1 |
| Antibody Type | Primary antibody |
| Storage | Store at 4°C short term. Aliquot and store at -20°C long term. Avoid freeze/thaw cycles. |
| Species Reactivity | Human,Mouse,Rat,Rabbit |
| Immunogen | Purified recombinant fragment of human CHRNA7 (AA: extra 52-259) expressed in E. Coli. |
| Formulation | Purified antibody in PBS with 0.05% sodium azide |
Application |
|
|---|---|
| IHC | 1/100 - 1/500 |
| FCM | 1/200 - 1/400 |
| ELISA | 1/10000 |
Product Image
-
Black line: Control Antigen (100 ng);Purple line: Antigen (10ng); Blue line: Antigen (50 ng); Red line:Antigen (100 ng)

-
Flow cytometric analysis of SH-SY5Y cells using CHRNA7 mouse mAb (green) and negative control (red).

-
Immunohistochemical analysis of paraffin-embedded human bladder cancer tissues using CHRNA7 mouse mAb with DAB staining.

-
Immunohistochemical analysis of paraffin-embedded human rectum cancer tissues using CHRNA7 mouse mAb with DAB staining.

-
Immunohistochemical analysis of paraffin-embedded Mouse kidney using CHRNA7 mouse mAb with DAB staining.

-
Immunohistochemical analysis of paraffin-embedded Rat kidney using CHRNA7 mouse mAb with DAB staining.

-
Immunohistochemical analysis of paraffin-embedded Rabbit kidney using CHRNA7 mouse mAb with DAB staining.

鄂公网安备42018502007531号

